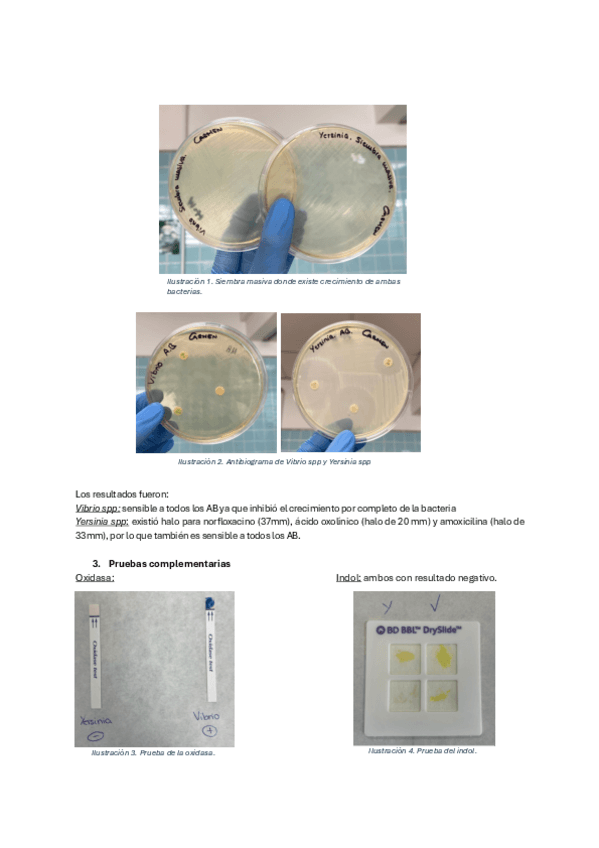

Clínica y sanidad en animales acuáticos
He publicado nuevos practicas de 5º Clínica y sanidad en animales acuáticos: Practicas-1-3.1.pdf
He publicado nuevos practicas de 5º Clínica y sanidad en animales acuáticos: Practicas-3.2-4.pdf
He publicado nuevos examenes de 5º Clínica y sanidad en animales acuáticos: Pregunta-Elvira.pdf
practicas
-
Memorias de prácticas
He publicado nuevos practicas de 5º Clínica y sanidad en animales acuáticos: Memorias de prácticas
He publicado nuevos apuntes de 5º Clínica y sanidad en animales acuáticos: Apuntes-acuaticos.pdf
apuntes
-
ACUÁTICOS COMPLETO
He publicado nuevos apuntes de 5º Clínica y sanidad en animales acuáticos: ACUÁTICOS COMPLETO
He publicado nuevos examenes de 5º Clínica y sanidad en animales acuáticos: Preguntas-examen-practico.pdf
apuntes
-
Apuntes por temas 2023
He publicado nuevos apuntes de 5º Clínica y sanidad en animales acuáticos: Apuntes por temas 2023
apuntes
-
Resumen TEMARIO+ preguntas cortas
He publicado nuevos apuntes de 5º Clínica y sanidad en animales acuáticos: Resumen TEMARIO+ preguntas cortas
He publicado nuevos examenes de 5º Clínica y sanidad en animales acuáticos: Preguntas-acuaticos.pdf
He publicado nuevos examenes de 5º Clínica y sanidad en animales acuáticos: Bateria-TIPO-TEST-alumnos1920.pdf
He publicado nuevos apuntes de 5º Clínica y sanidad en animales acuáticos: Temario-acuaticos.docx
apuntes
-
Esquemas
He publicado nuevos apuntes de 5º Clínica y sanidad en animales acuáticos: Esquemas
apuntes
-
Práctico
He publicado nuevos apuntes de 5º Clínica y sanidad en animales acuáticos: Práctico
apuntes
-
Acuáticos
He publicado nuevos apuntes de 5º Clínica y sanidad en animales acuáticos: Acuáticos
He publicado nuevos apuntes de 5º Clínica y sanidad en animales acuáticos: Tema-8.pdf
He publicado nuevos apuntes de 5º Clínica y sanidad en animales acuáticos: Tema-7.pdf
He publicado nuevos apuntes de 5º Clínica y sanidad en animales acuáticos: Tema-6.pdf
He publicado nuevos apuntes de 5º Clínica y sanidad en animales acuáticos: Tema-5-8-C.pdf
He publicado nuevos apuntes de 5º Clínica y sanidad en animales acuáticos: Tema-4.pdf
He publicado nuevos apuntes de 5º Clínica y sanidad en animales acuáticos: Tema-3.pdf
He publicado nuevos apuntes de 5º Clínica y sanidad en animales acuáticos: Tema-2.pdf
apuntes
-
Tema 1. Jeronimo
He publicado nuevos apuntes de 5º Clínica y sanidad en animales acuáticos: Tema 1. Jeronimo
He publicado nuevos apuntes de 5º Clínica y sanidad en animales acuáticos: Nacho4.pdf
He publicado nuevos apuntes de 5º Clínica y sanidad en animales acuáticos: Nacho3.pdf
He publicado nuevos apuntes de 5º Clínica y sanidad en animales acuáticos: Nacho2.pdf
He publicado nuevos apuntes de 5º Clínica y sanidad en animales acuáticos: Nacho.pdf
practicas
-
Prácticas
He publicado nuevos practicas de 5º Clínica y sanidad en animales acuáticos: Prácticas
He publicado nuevos apuntes de 5º Clínica y sanidad en animales acuáticos: Temario-completo-Clinica-Acuaticos.pdf
He publicado nuevos examenes de 5º Clínica y sanidad en animales acuáticos: PREGUNTAS-test-CLINICA-DE-ACUATICOS18-19-1.pdf
He publicado nuevos examenes de 5º Clínica y sanidad en animales acuáticos: Bateria-TIPO-TEST-alumnos1920.pdf
He publicado nuevos apuntes de 5º Clínica y sanidad en animales acuáticos: APUNTES.pdf
He publicado nuevos apuntes de 5º Clínica y sanidad en animales acuáticos: teoria-examen.pdf
He publicado nuevos apuntes de 5º Clínica y sanidad en animales acuáticos: tablas.pdf
examenes
-
Examen MODELO
He publicado nuevos examenes de 5º Clínica y sanidad en animales acuáticos: Examen MODELO

¡Estás al día!
Has visto todos los archivos